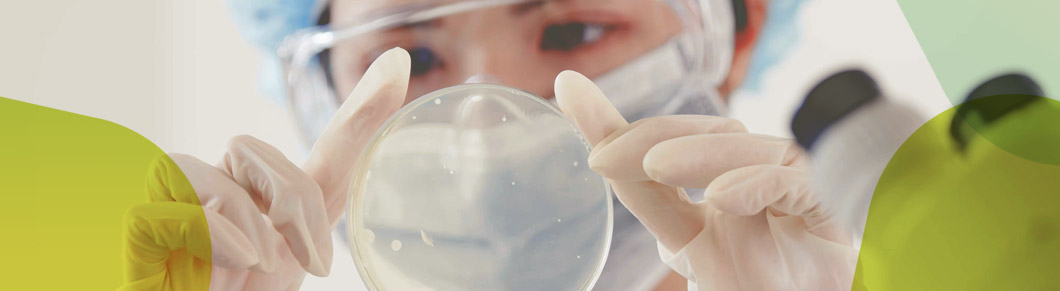
A representative photograph of developing a professional medicine.

GC Biopharma Operations Today
Unlimited dedication
To the development of safer,
More
effective treatments.
R&D
Convinced that R&D is the source of future revenue and national economic growth, GC Biopharma has been leading the pharmaceutical industry in Korea with its bold and aggressive strategies in this area. GC Biopharma R&D Center, the cradle of major R&D activities throughout the GC, and other research-specialized subsidiaries continue to recruit talented researchers and strengthen their core capabilities for research. GC Biopharma will continue to invest actively in the development of new drugs and biologics and secure its reputation worldwide as a pioneer in biotechnology dedicated to good health for all.
Investment(in KRW 100 million)

-
- GC MS
- GC Wellbeing
- GCMedis
-
- Overseas
- GC China Pharm
- Curevo
- GC Pharma do Brasil
-
- Foundation
- MOGAM Institue
- GC Labs
- GC i-Med
-
- Others
- GC Invacfarm

